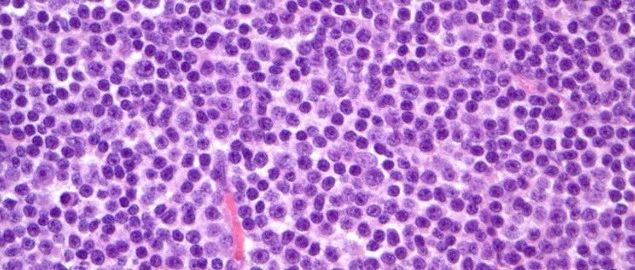

弥漫性大B细胞淋巴瘤!
医学影像 yxyx-app 医学影像APP,打造伴随医生快速成长的影像学习社区。与影像园(Xctmr.com)一起提供最全面的影像案例库、基础(解剖、病理、影像诊断)知识、影像技术及考题等,为医生提供最佳的医学影像参考。【所属科室】神经外科【基本资料】患者,男,53岁【主诉】进行性头晕、走路不稳伴间断呕吐1个月,视物成双1周【专科检查】双眼视力粗测正常,水平眼震,双瞳孔等大正圆,光反射灵敏,左眼外展受限。左侧面部(V1,2,3)感觉减退,左耳听力粗测下降,左侧味觉减退,伸舌居中。双侧腹壁反射消失、右侧提睾反射消失、左侧提睾反射减弱。四肢肌力5级,左侧肢体共济运动障碍。双侧病理征阴性。...
【精彩预告】大咖齐聚——规范化诊疗人才建设巡讲第九场与您相约,敬请期待!
据统计,中国淋巴瘤患者的5年总生存(OS)率为35%左右,低于美国和日本等国家,进一步提高患者生存期任重而道远。随着新药的不断涌现,淋巴瘤诊疗正逐步迈向精准和靶向治疗时代。2023年1月18日,全球首个获批上市的CD30靶向抗体偶联药物(ADC)——维布妥昔单抗正式被纳入医保,为中国淋巴瘤患者提供了治疗新选择,有望延长患者生存。但目前我国仍然面临地区及医院之间诊疗水平差异较大的问题,因此淋巴瘤规范化诊疗建设势在必行。为提升全国各层级医院诊疗水平,助力临床医生提高淋巴瘤患者全程管理能力,由中国人体健康科技促进会主办的“...
【精彩预告】大咖齐聚——规范化诊疗人才建设巡讲第八场与您相约,敬请期待!
据统计,中国淋巴瘤患者的5年总生存(OS)率为35%左右,低于美国和日本等国家,进一步提高患者生存期任重而道远。随着新药的不断涌现,淋巴瘤诊疗正逐步迈向精准和靶向治疗时代。2023年1月18日,全球首个获批上市的CD30靶向抗体偶联药物(ADC)——维布妥昔单抗正式被纳入医保,为中国淋巴瘤患者提供了治疗新选择,有望延长患者生存。但目前我国仍然面临地区及医院之间诊疗水平差异较大的问题,因此淋巴瘤规范化诊疗建设势在必行。为提升全国各层级医院诊疗水平,助力临床医生提高淋巴瘤患者全程管理能力,由中国人体健康科技促进会主办的“...
肺癌患者注意了!2023年3月1日起,这18种抗癌药可以报销
2023年1月18日,国家医保局发布了最新的2022年医保药品目录。其中肺癌新增了3种抗癌新药首次进入医保,2023年肺癌抗癌药进入医保报销范围内的共有18种药。以下为这18种药的医保报销适应症范围(仅限肺癌相关适应症):甲磺酸奥希替尼片医保报销适应症:表皮生长因子受体(EGFR)外显子19缺失或外显子21(L858R)置换突变的局部晚期或转移性非小细胞肺癌(NSCLC)成人患者的一线治疗;既往因表皮生长因子受体(EGFR)酪氨酸激酶抑制剂(TKI)治疗时或治疗后出现疾病进展,并且经检验确认存在EGFR T790M突变阳性的局部晚期或转移性非小细胞肺癌成人患者的治疗。...